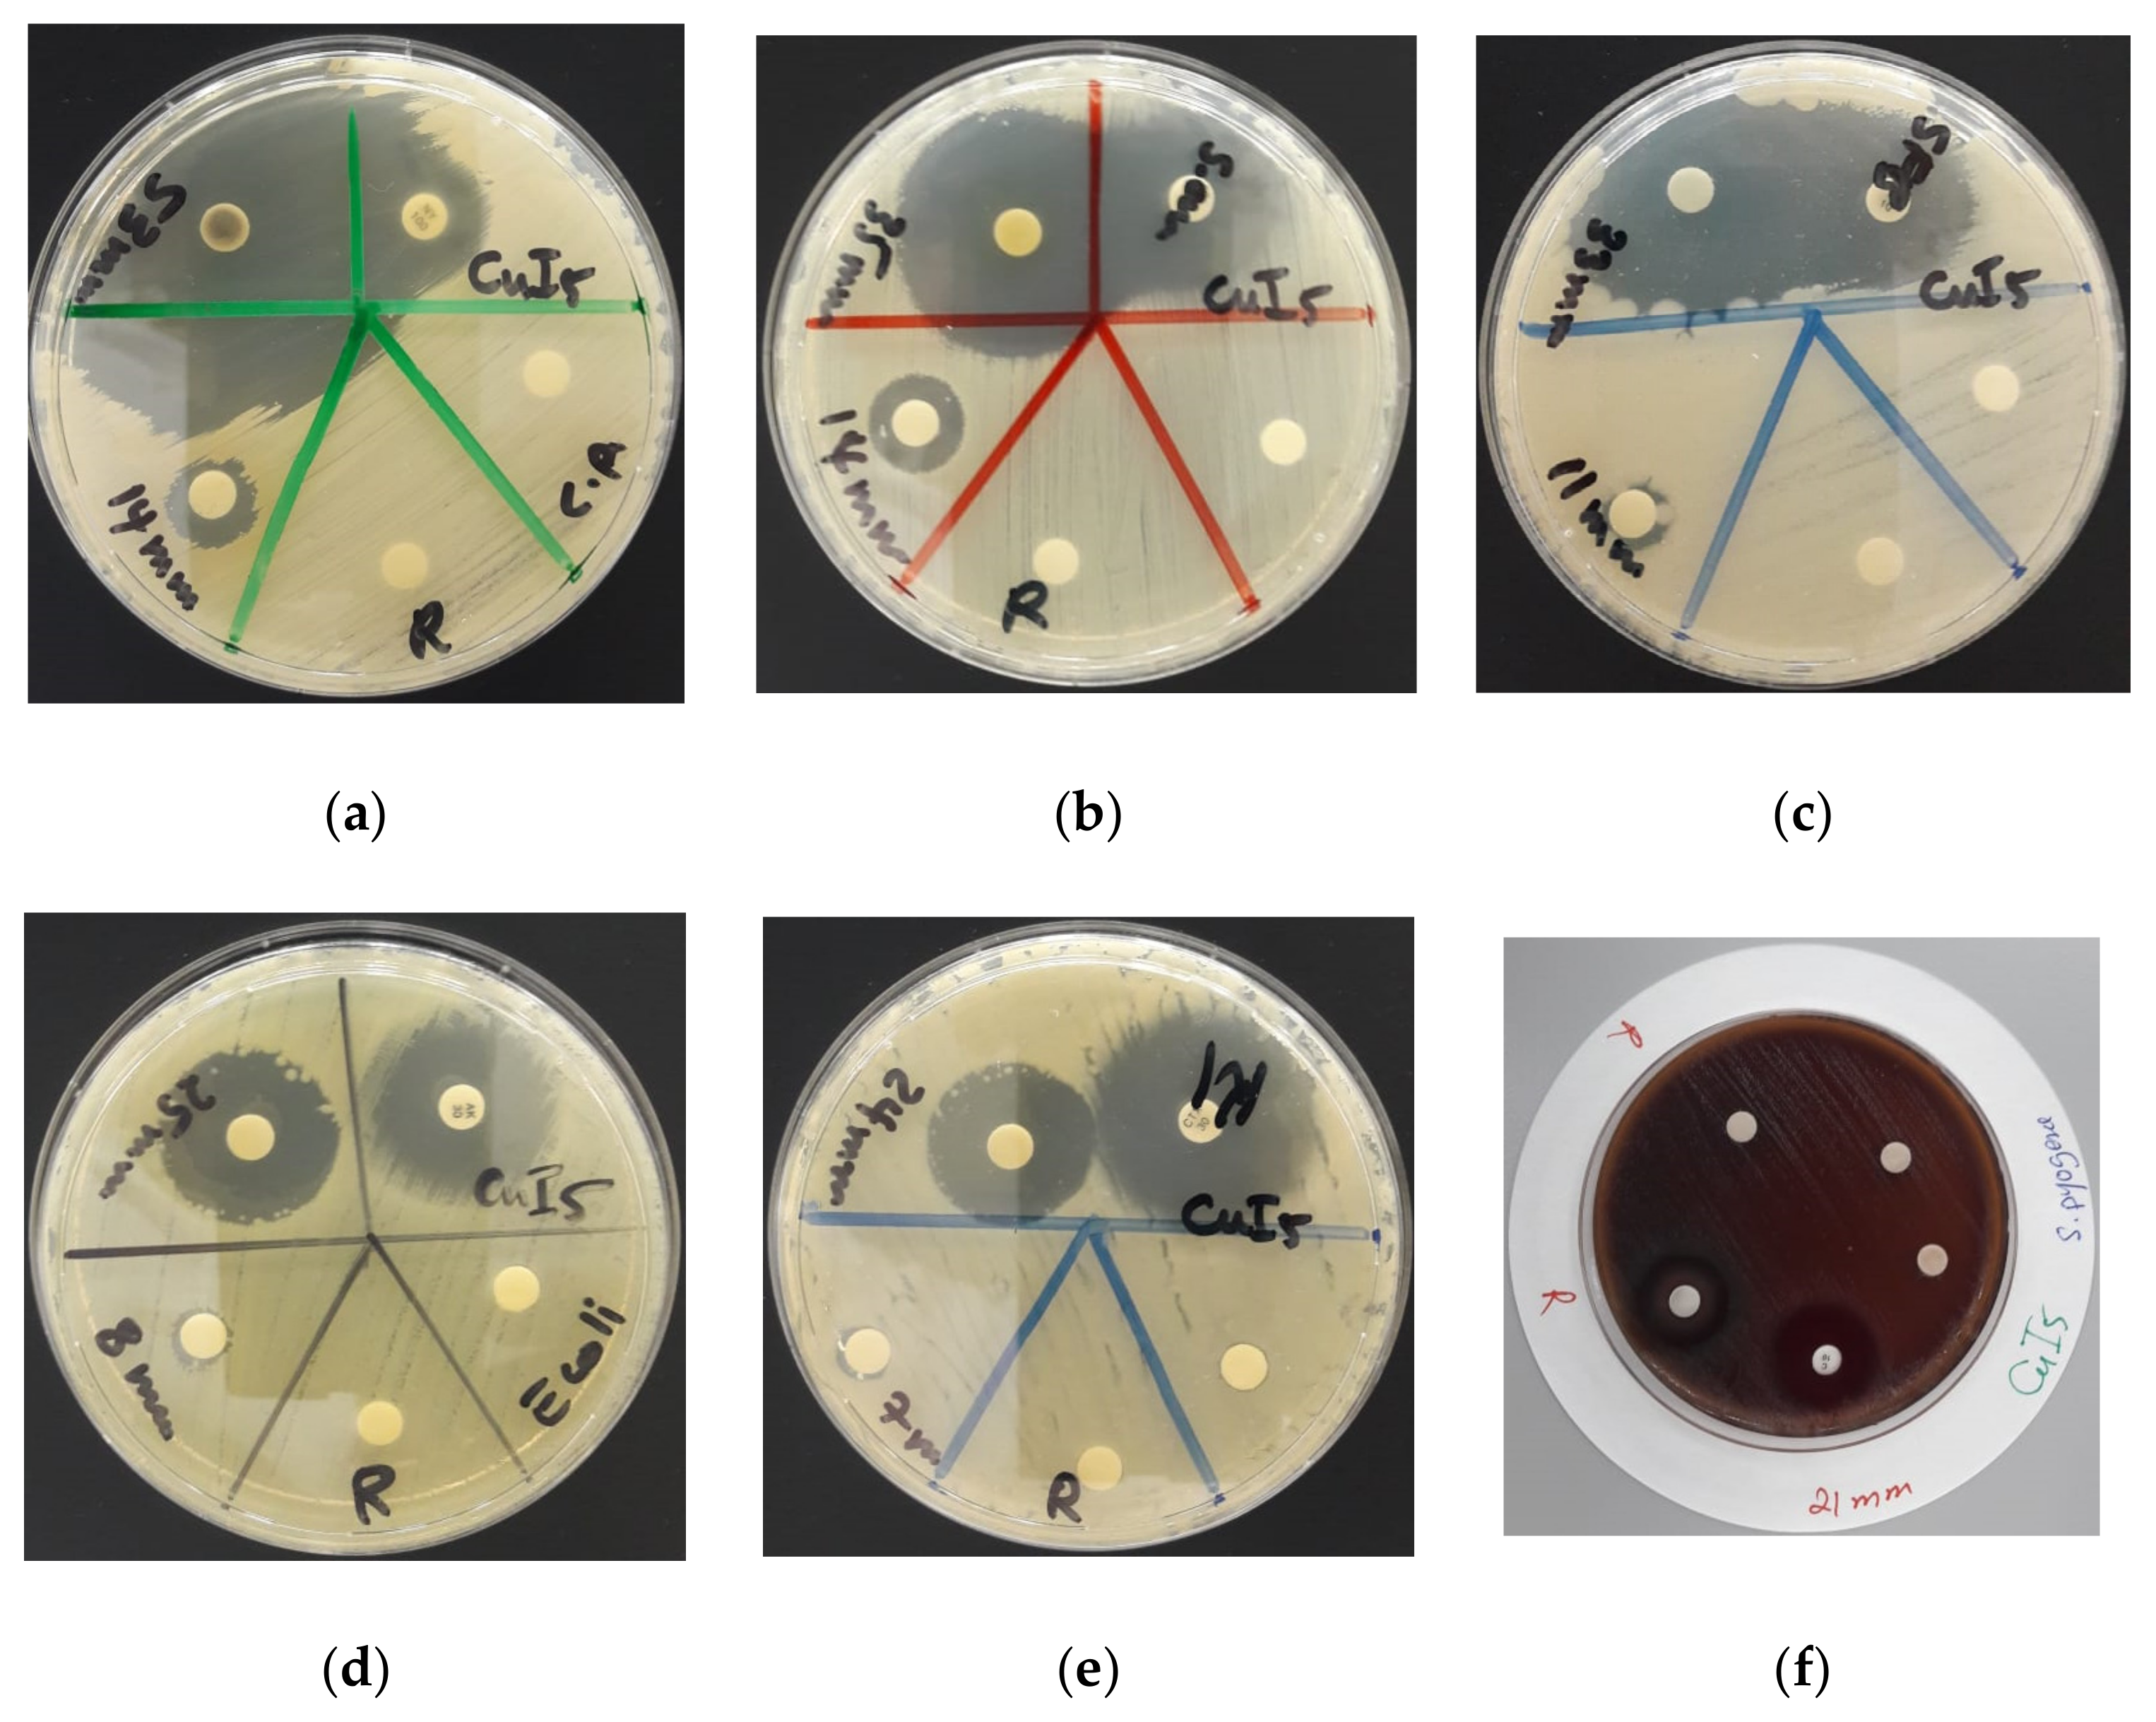
Polymers 13 01005 g006 Polymers 13 01005 g006

Antimicrobial Hexaaquacopper(II) Complexes with Novel Polyiodide Chains
Abstract
1. Introduction
2. Materials and Methods
2.1. Chemicals
2.2. Preparation of [Cu(H2O)6(12-crown-4)5]I6 · 2I2
2.3. Characterization of the Compound
2.3.1. Electron Microscope (SEM) and Energy-Dispersive X-ray Spectroscopic (EDS) Analysis
2.3.2. Nuclear Magnetic Resonance (NMR) Spectroscopy
2.3.3. Characterization by Raman Spectroscopy (Raman)
2.3.4. Fourier-Transform Infrared (FTIR) Spectroscopy
2.3.5. Crystal Structure Analysis
2.4. Investigation/Determination of Antibacterial and Antifungal Properties of [Cu(H2O)6(12-crown-4)5]I6 · 2I2
2.4.1. Bacterial Strains and Culturing
2.4.2. Procedure for Zone of Inhibition (ZOI) Plate Studies
2.4.3. Agar Well Diffusion Method
2.4.4. Disc Diffusion Method
2.5. Statistical Analysis
3. Results and Discussion
3.1. Elemental Composition and Morphological Examination
Electron Microscope (SEM) and Energy-Dispersive X-ray Spectroscopic (EDS) Analysis
3.2. Spectroscopical Characterization
3.2.1. Nuclear Magnetic Resonance (NMR) Spectroscopy
3.2.2. Raman Spectroscopy (Raman)
3.2.3. Fourier-Transform Infrared (FTIR) Spectroscopy
3.3. Cyrstal Structure Determination
Crystal Structure Analysis
3.4. Determination of Antimicrobial Activities of [Cu(12-crown-4)5(H2O)6]I6 · 2I2
4. Conclusions
Supplementary Materials
Author Contributions
Funding
Institutional Review Board Statement
Informed Consent Statement
Data Availability Statement
Acknowledgments
Conflicts of Interest
References
- Cassini, A.; Hogberg, L.D.; Plachouras, D.; Quattrocchi, A.; Hoxha, A.; Simonsen, G.S.; Colomb-Cotinat, M.; Kretzschmar, M.E.; Devleesschauwer, B.; Cecchini, M.; et al. Attributable deaths and disability-adjusted life-years caused by infections with antibiotic-resistant bacteria in the EU and the European Economic Area in 2015: A population-level modelling analysis. Lancet Infect. Dis. 2019, 19, 56–66. [Google Scholar] [CrossRef]
- Center for Disease Control and Prevention (USA). Antibiotic Resistance Threats in the United States. Available online: https://www.cdc.gov/drugresistance/biggest-threats.html (accessed on 15 August 2020).
- Mulani, M.S.; Kamble, E.E.; Kumkar, S.N.; Tawre, M.S.; Pardesi, K.R. Emerging Strategies to Combat ESKAPE Pathogens in the Era of Antimicrobial Resistance: A Review. Front. Microbiol. 2019, 10, 539–563. [Google Scholar] [CrossRef]
- Kourtis, A.P.; Hatfield, K.; Baggs, J.; Mu, Y.; See, I.; Epson, E.; Nadle, J.; Kainer, M.A.; Dumyati, G.; Petit, S. Vital Signs: Epidemiology and Recent Trends in Methicillin-Resistant and in Methicillin-Susceptible Staphylococcus aureus Bloodstream Infections—United States. Morb. Mortal. Wkly. Rep. 2019, 68, 214. [Google Scholar] [CrossRef]
- Touat, M.; Opatowski, M.; Brun-Buisson, C.; Cosker, K.; Guillemot, D.; Salomon, J.; Tuppin, P.; de Lagasnerie, G.; Watier, L. A payer perspective of the hospital inpatient additional care costs of antimicrobial resistance in France: A matched case–control study. Appl. Heal. Econ. Health Policy 2019, 17, 381–389. [Google Scholar] [CrossRef] [PubMed]
- Rawson, T.M.; Moore, L.S.P.; Zhu, N.; Ranganathan, N.; Skolimowska, K.; Gilchrist, M.; Satta, G.; Cooke, G.; Holmes, A. Bacterial and fungal co-infection in individuals with coronavirus: A rapid review to support COVID-19 antimicrobial prescribing. Clin. Infect. Dis. 2020. [Google Scholar] [CrossRef]
- Barranco, R.; Du Tremoul, L.; Ventura, F. Hospital-Acquired SARS-Cov-2 Infections in Patients: Inevitable Conditions or Medical Malpractice? Int. J. Environ. Res. Public Health 2021, 18, 489. [Google Scholar] [CrossRef] [PubMed]
- Bloukh, S.H.; Edis, Z.; Shaikh, A.A.; Pathan, H.M. A Look Behind the Scenes at COVID-19: National Strategies of Infection Control and Their Impact on Mortality. Int. J. Environ. Res. Public Health 2020, 17, 5616. [Google Scholar] [CrossRef]
- Kamaruzzaman, N.F.; Tan, L.P.; Hamdan, R.H.; Choong, S.S.; Wong, W.K.; Gibson, A.J.; Chivu, A.; Pina, M.F. Antimicrobial Polymers: The Potential Replacement of Existing Antibiotics? Int. J. Mol. Sci. 2019, 20, 2747. [Google Scholar] [CrossRef] [PubMed]
- Arora, S.; Yadav, V.; Kumar, P.; Gupta, R.; Kumar, D. Polymer based antimicrobial coatings as potential biomaterial: A review. Int. J. Pharm. Sci. Rev. Res. 2013, 23, 279–290. [Google Scholar]
- Edis, Z.; Bloukh, S.H. Facile Synthesis of Antimicrobial Aloe Vera- “Smart” Triiodide-PVP Biomaterials. Biomimetics 2020, 5, 45. [Google Scholar] [CrossRef] [PubMed]
- Li, X.; Wang, B.; Liang, T.; Wang, R.; Song, P.; He, Y. Synthesis of cationic acrylate copolyvidone-iodine nanoparticles with double active centers and their antibacterial application. Nanoscale 2020, 12, 21940–21950. [Google Scholar] [CrossRef]
- Edis, Z.; Bloukh, S.H.; Ashames, A.; Ibrahim, M. Copper-Based Nanoparticles, Their Chemistry and Antibacterial Properties: A Review. In Chemistry for a Clean and Healthy Planet; Springer International: Berlin/Heidelberg, Germany, 2019; pp. 401–428. [Google Scholar]
- Zhao, G.; He, C.; Zhou, W.; Hooper, J.P.; Imler, G.H.; Parrish, D.A.; Shreeve, J.M. Control of Biohazards: A High Performance Energetic Polycyclized Iodine-Containing Biocide. Inorg. Chem. 2018, 57, 8673–8680. [Google Scholar] [CrossRef] [PubMed]
- Kaiho, T. Iodine Chemistry and Applications, 1st ed.; Kaiho, T., Ed.; John Wiley & Sons, Inc.: Hoboken, NJ, USA, 2015; pp. 15–410. [Google Scholar]
- Vasudevan, P.; Tandon, M. Antimicrobial properties of iodine based products. J. Sci. Ind. Res. 2010, 69, 376–383. [Google Scholar]
- Blake, A.J.; Li, W.S.; Lippolis, V.; Schröder, M.; Devillanova, F.A.; Gould, R.O.; Parsons, S.; Radek, C. Template self-assembly of polyiodide networks. Chem. Soc. Rev. 1998, 27, 195–206. [Google Scholar] [CrossRef]
- Svensson, P.H.; Kloo, L. Synthesis, structure, and bonding in polyiodide and metal iodide−iodine systems. Chem. Rev. 2003, 103, 1649–1684. [Google Scholar] [CrossRef]
- Resnati, G.; Desiraju, G.R.; Ho, P.S.; Kloo, L.; Legon, A.C.; Marquardt, R.; Metrangolo, P.; Politzer, P.; Rissanen, K. Definition of the halogen bond. Pure Appl. Chem. 2013, 85, 1711–1713. [Google Scholar]
- Bartashevich, E.V.; Grigoreva, E.A.; Yushina, I.D.; Bulatova, L.M.; Tsirelson, V.G. Modern level for the prediction of properties of iodine-containing organic compounds: Iodine forming halogen bonds. Russ. Chem. Bull. Int. Ed. 2017, 66, 1–12. [Google Scholar] [CrossRef]
- Savastano, M.; Bazzicalupi, C.; Gellini, C.; Bianchi, A. Genesis of Complex Polyiodide Networks: Insights on the Blue Box/I−/I2 Ternary System. Crystals 2020, 10, 387. [Google Scholar] [CrossRef]
- Shestimerova, T.A.; Mironov, A.V.; Bykov, M.A.; Grigorieva, A.V.; Wei, Z.; Dikarev, E.V.; Shevelkov, A.V. Assembling Polyiodides and Iodobismuthates Using a Template Effect of a Cyclic Diammonium Cation and Formation of a Low-Gap Hybrid Iodobismuthate with High Thermal Stability. Molecules 2020, 25, 2765. [Google Scholar] [CrossRef]
- Savastano, M.; Martínez-Camarena, Á.; Bazzicalupi, C.; Delgado-Pinar, E.; Llinares, J.M.; Mariani, P.; Verdejo, B.; García-España, E.; Bianchi, A. Stabilization of Supramolecular Networks of Polyiodides with Protonated Small Tetra-azacyclophanes. Inorganics 2019, 7, 48. [Google Scholar] [CrossRef]
- Bartashevich, E.; Yushina, I.; Kropotina, K.; Muhitdinova, S.; Tsirelson, V. Testing the tools for revealing and characterizing the iodine–iodine halogen bond in crystals. Acta Crystallogr. B 2017, 73, 217–226. [Google Scholar] [CrossRef] [PubMed]
- Van Mengen, M.; Reiss, G.J. I62− Anion composed of two asymmetric triiodide moieties: A competition between halogen and hydrogen bond. Inorganics 2013, 1, 3–13. [Google Scholar] [CrossRef]
- Reiss, G.J. Halogen and hydrogen bonding in the layered crystal structure of 2-iodoaniliniumtriiodide, C6H7I4N. Z. Kristallogr. NCS 2019, 234, 899–902. [Google Scholar]
- Edis, Z.; Bloukh, S.H.; Abu Sara, H.; Bhakhoa, H.; Rhyman, L.; Ramasami, P. “Smart” triiodide compounds: Does halogen bonding influence antimicrobial activities? Pathogens 2019, 8, 182. [Google Scholar] [CrossRef] [PubMed]
- Edis, Z.; Bloukh, S.H. Preparation and structural and spectroscopic characterization of triiodides [M(12-crown-4)2]I3 with M = Na and Rb. Z. Nat. 2014, 69, 995–1002. [Google Scholar]
- Bloukh, S.H.; Edis, Z. Halogen bonding in Crystal structure of bis(1,4,7,10-tetraoxacyclododecane-κ4O,O′,O′′,O′′′)cesium triiodide, C16H32CsI3O8. Z. Kristallogr. NCS 2020, 235, 717–719. [Google Scholar] [CrossRef]
- Edis, Z.; Bloukh, S.H. Preparation and structural and spectroscopic characterization of a pentaiodide [Rb(12-crown-4)2]I5. Z. Nat. 2013, 68, 1340–1346. [Google Scholar]
- Bloukh, S.H.; Edis, Z. Structure and Antimicrobial properties of bis(1,4,7,10-tetraoxacyclododecane-κ4O,O′,O′′,O′′′)cesium pentaiodide, C16H32CsI5O8. Z. Kristallogr. NCS 2020, 235, 759–761. [Google Scholar] [CrossRef]
- Edis, Z. Polyiodides of 12-Crown-4 Complexes with Alkali Cations. Ph.D. Thesis, University of Cologne, Cologne, Germany, July 1999. [Google Scholar]
- Oxford Diffraction: CrysAlisPRO; Version 1.171.33.42; Oxford Diffraction Ltd.: Oxford, UK, 2009.
- Sheldrick, G.M. A short history of SHELX. Acta Crystallogr. A 2008, 64, 112–122. [Google Scholar] [CrossRef]
- Sheldrick, G.M. Crystal structure refinement with SHELXL. Acta Crystallogr. C 2015, 71, 3–8. [Google Scholar] [CrossRef] [PubMed]
- Hübschle, C.B.; Sheldrick, G.M.; Dittrich, B. ShelXle: A Qt graphical user interface for SHELXL. J. Appl. Crystallogr. 2011, 44, 1281–1284. [Google Scholar] [CrossRef]
- Brandenburg, K. DIAMOND. Visual Crystal Structure Information System; Ver. 4.5.2; Crystal Impact: Bonn, Germany, 2018. [Google Scholar]
- Bauer, A.W.; Perry, D.M.; Kirby, W.M.M. Single-disk antibiotic-sensitivity testing of staphylococci: An analysis of technique and results. AMA Arch. Intern. Med. 1959, 104, 208–216. [Google Scholar] [CrossRef]
- Clinical and Laboratory Standards Institute (CLSI). Performance Standards for Antimicrobial Disk Susceptibility Testing, 28th ed.; CLSI: Wayne, PA, USA, 2018; Volume 38. [Google Scholar]
- Deplano, P.; Devillanova, F.; Francesco, A.; Ferraro, J.R.; Mercuri, M.L.; Lippolis, V.; Trogu, E.F. FT-Raman Study on Charge-Transfer Polyiodide Complexes and Comparison with Resonance Raman Results. Appl. Spectrosc. 1994, 48, 1236–1241. [Google Scholar] [CrossRef]
- Nour, E.M.; Chen, L.H.; Laane, J. Far-infrared and Raman spectroscopic studies of polyiodide. J. Phys. Chem. 1986, 90, 2841–2846. [Google Scholar] [CrossRef]
- Mittag, H.; Stegemann, H.; Füllbier, H.; Irmer, G. Raman spectroscopic investigation of n-alkylurotro-pinium polyiodides. J. Raman Spectrosc. 1989, 20, 251–255. [Google Scholar] [CrossRef]
- Zhang, S.; Kai, C.; Liu, B.; Zhang, S.; Wei, W.; Xu, X.; Zhou, Z. Facile fabrication of cellulose membrane containing polyiodides and its antibacterial properties. Appl. Surf. Sci. 2020, 500, 144046. [Google Scholar] [CrossRef]
- Yushina, I.D.; Kolesov, B.A.; Bartashevich, E.V. Raman spectroscopy study of new thia- and oxazinoquinolinium triodides. New J. Chem. 2015, 39, 6163–6170. [Google Scholar] [CrossRef]
- Seki, T.; Chiang, K.-Y.; Yu, C.-C.; Yu, X.; Okuno, M.; Hunger, J.; Nagata, Y.; Bonn, M. The Bending Mode of Water: A Powerful Probe for Hydrogen Bond Structure of Aqueous Systems. J. Phys. Chem. Lett. 2020, 11, 8459–8469. [Google Scholar] [CrossRef] [PubMed]
- Reiss, G.J. Crystal structure of bis(1,3-phenylenedimethanaminium) bis(triiodide) tetraiodide-water (1/2), C8H16I5N2O. Z. Kristallogr. NCS 2020, 235, 1047–1050. [Google Scholar] [CrossRef]
- Van Megen, M.; Jablonka, A.; Reiss, G.J. Synthesis, Structure and Thermal Decomposition of a New Iodine Inclusion Compound in the 2,2-Dimethylpropane-1,3-diamine/HI/I2 System. Z. Naturforsch. B 2014, 69, 753–760. [Google Scholar] [CrossRef]
- Reiss, G.J. A cyclic I102− anion in the layered crystal structure of theophyllinium pentaiodide, C7H9I5N4O2. Z. Kristallogr. NCS 2019, 234, 737–739. [Google Scholar] [CrossRef]
- Reiss, G.J. I5––polymers with a layered arrangement: Synthesis, spectroscopy, and structure of a new polyiodide salt in the nicotine/HI/I2 system. Z. Naturforsch. B 2015, 70, 735–739. [Google Scholar] [CrossRef]
- Reiss, G.J.; van Megen, M. Two New Polyiodides in the 4,4′-Bipyridinium Diiodide/Iodine System. Z. Naturforsch. B 2012, 67, 5–10. [Google Scholar]
- Horn, C.; Scudder, M.; Dance, I. Crystal structures, crystal packing and supramolecular motifs in [Fe(phen)]I14 and [M(phen)]I18 (M = Fe, Ni): Complementary orthogonality of [M(phen)] cations and polyiodide anions. Cryst. Eng. Comm. 2001, 3, 3–9. [Google Scholar] [CrossRef]
- Bloukh, S.H.; Edis, Z.; Ibrahim, M.R.; Abu Sara, H. “Smart” antimicrobial nanocomplexes with potential to decrease surgical site infections (SSI). Pharmaceutics 2020, 12, 361. [Google Scholar] [CrossRef]
- Lachapelle, J.M.; Castel, O.; Casado, A.F.; Leroy, B.; Micali, G.; Tennstedt, D.; Lambert, J. Antiseptics in the era of bacterial resistance: A focus on povidone iodine. Clin. Pract. 2013, 10, 579–592. [Google Scholar] [CrossRef]
- Santajit, S.; Indrawattana, N. Mechanisms of antimicrobial resistance in ESKAPE pathogens. Biomed. Res. Int. 2016, 2016, 2475067. [Google Scholar] [CrossRef]

| Group | 1 | [43] | [44] | [22] | [20] |
|---|---|---|---|---|---|
| I2 | 172 νs | 172 νs | 172 νs | ||
| I3− | 217 νas 331 νas | 227 νas 340 νas | |||
| I5− | 142 νas | 147 νas | 137 νas | 134 νas | |
| 12-crown-4 | 2855 |
| ν1 (O–H) * s ν2 (O–H) * a | ν (C–H)a | ν (CH2)a,s | ν (C-H)s ν (O-H) * | δ (C-H)a ν3 (H-O-H) * | (C-C) | δ (C-H) δ (C-C) | ν (C-O) | ν (CH-CH) ν (O-H) * | |
|---|---|---|---|---|---|---|---|---|---|
| A | 2940 | 2909 | 2860 | 1459 | 1375 | 1290 | 1250 1140 1100 1025 919 | 848 | |
| B | 3746 * s 3418 * a | 2951 | 2905 | 2863 2777 * 2733 * | 1443 1642 * | 1360 | 1287 | 1243 1133 1092 1022 911 | 844 549 * 628 * |
| Item | Parameter |
|---|---|
| Formula | C40H92CuI10O26 |
| Mr | 1160.84 |
| Linear absorption factor | µ = 4.64 mm−1 |
| Crystal system, space group | Triclinic , P-1 |
| a | 10.7289 (4) Å |
| b | 12.3645 (5) Å |
| c | 15.1570 (7) Å |
| α | 113.470 (4)° |
| β | 99.187 (4)° |
| γ | 92.543 (3)° |
| Temp. | 100 K |
| Volume, Z | V = 1807.70 (14) Å3, Z = 1 |
| Diffractometer | Xcalibur |
| Radiation | Mo Kα, λ = 0.71073 Å |
| Measured reflections | 17,571 |
| Independent reflections | 7846 |
| Reflections with I > 2σ(I) | 5930 |
| Rint; Completeness | 0.042; 99.3% |
| Refined parameters | 371 |
| R[F2 > 2σ(F2)] | 0.042 |
| wR(F2); GooF | 0.081, 1.05 |
| Δρmax; Δρmin | 0.86 e Å−3; −0.87 e Å−3 |
| Strain | Antibiotic | A | AW + | 1 + | 2 + | 3 + |
|---|---|---|---|---|---|---|
| S. pneumoniae ATCC 49619 | G | 18 | 20 | 19 | 0 | 0 |
| S. aureus ATCC 25923 | G | 28 | 23 | 35 | 14 | 0 |
| S. pyogenes ATCC 19615 | C | 25 | 20 | 21 | 0 | 0 |
| E. faecalis ATCC 29212 | CTX | 25 | 19 | 18 | 0 | 0 |
| B. subtilis WDCM 00003 | S | 20 | 21 | 33 | 11 | 0 |
| P. mirabilis ATCC 29906 | G | 25 | 0 | 15 | 0 | 0 |
| P. aeruginosa WDCM 00026 | CTX | 21 | 16 | 12 | 0 | 0 |
| E. coli WDCM 00013 | A | 20 | 15 | 25 | 8 | 0 |
| K. pneumoniae WDCM 00097 | CTX | 17 | NA | 24 | 7 | 0 |
| C. albicans WDCM 00054 | NY | 16 | 51 | 53 | 14 | 0 |
Publisher’s Note: MDPI stays neutral with regard to jurisdictional claims in published maps and institutional affiliations. |
© 2021 by the authors. Licensee MDPI, Basel, Switzerland. This article is an open access article distributed under the terms and conditions of the Creative Commons Attribution (CC BY) license (http://creativecommons.org/licenses/by/4.0/).
Share and Cite
Edis, Z.; Raheja, R.; Bloukh, S.H.; Bhandare, R.R.; Sara, H.A.; Reiss, G.J. Antimicrobial Hexaaquacopper(II) Complexes with Novel Polyiodide Chains. Polymers 2021, 13, 1005. https://doi.org/10.3390/polym13071005
Edis Z, Raheja R, Bloukh SH, Bhandare RR, Sara HA, Reiss GJ. Antimicrobial Hexaaquacopper(II) Complexes with Novel Polyiodide Chains. Polymers. 2021; 13(7):1005. https://doi.org/10.3390/polym13071005
Chicago/Turabian StyleEdis, Zehra, Radhika Raheja, Samir Haj Bloukh, Richie R. Bhandare, Hamid Abu Sara, and Guido J. Reiss. 2021. "Antimicrobial Hexaaquacopper(II) Complexes with Novel Polyiodide Chains" Polymers 13, no. 7: 1005. https://doi.org/10.3390/polym13071005
APA StyleEdis, Z., Raheja, R., Bloukh, S. H., Bhandare, R. R., Sara, H. A., & Reiss, G. J. (2021). Antimicrobial Hexaaquacopper(II) Complexes with Novel Polyiodide Chains. Polymers, 13(7), 1005. https://doi.org/10.3390/polym13071005

